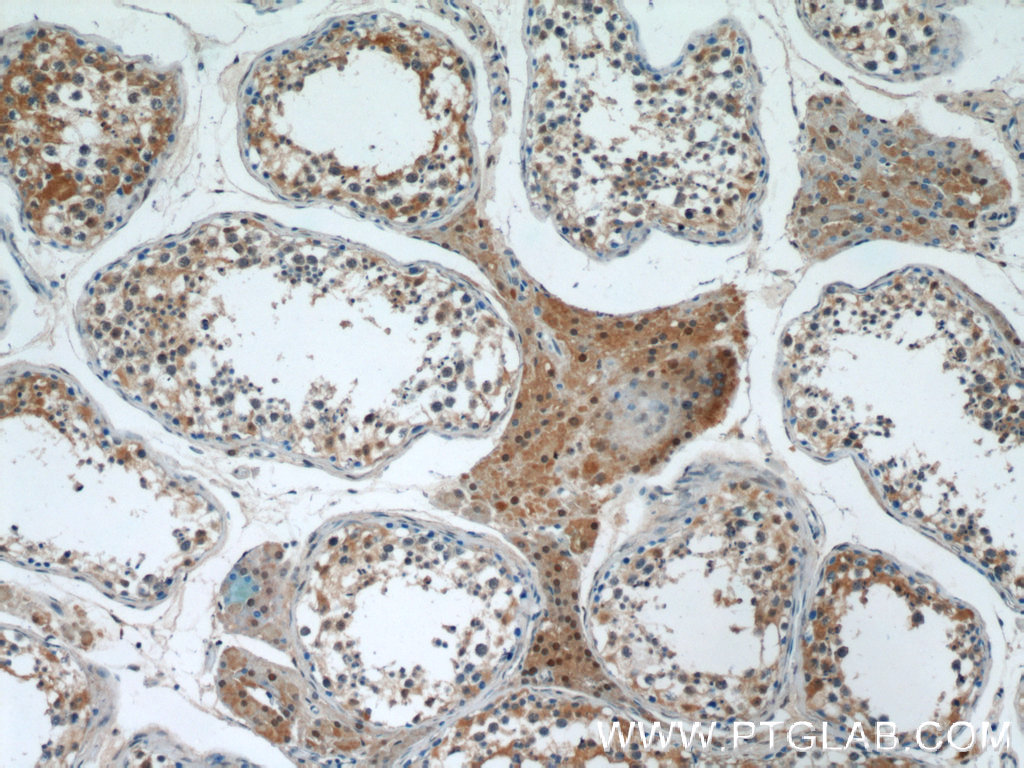

验证数据展示
经过测试的应用
| Positive WB detected in | HuH-7 cells, human testis tissue, HepG2 cells, fetal human brain tissue, pig liver tissue, rat brain tissue, rat liver tissue |
| Positive IHC detected in | mouse testis tissue, human testis tissue Note: suggested antigen retrieval with TE buffer pH 9.0; (*) Alternatively, antigen retrieval may be performed with citrate buffer pH 6.0 |
| Positive IF/ICC detected in | HepG2 cells |
推荐稀释比
| 应用 | 推荐稀释比 |
|---|---|
| Western Blot (WB) | WB : 1:5000-1:50000 |
| Immunohistochemistry (IHC) | IHC : 1:200-1:800 |
| Immunofluorescence (IF)/ICC | IF/ICC : 1:50-1:500 |
| It is recommended that this reagent should be titrated in each testing system to obtain optimal results. | |
| Sample-dependent, Check data in validation data gallery. | |
产品信息
66193-1-Ig targets GSNOR,ADH5 in WB, IHC, IF/ICC, CoIP, ELISA applications and shows reactivity with human, mouse, rat, pig samples.
| 经测试应用 | WB, IHC, IF/ICC, ELISA Application Description |
| 文献引用应用 | WB, IF, CoIP |
| 经测试反应性 | human, mouse, rat, pig |
| 文献引用反应性 | mouse, rat |
| 免疫原 |
CatNo: Ag9511 Product name: Recombinant human GSNOR,ADH5 protein Source: e coli.-derived, PET28a Tag: 6*His Domain: 1-374 aa of BC014665 Sequence: MANEVIKCKAAVAWEAGKPLSIEEIEVAPPKAHEVRIKIIATAVCHTDAYTLSGADPEGCFPVILGHEGAGIVESVGEGVTKLKAGDTVIPLYIPQCGECKFCLNPKTNLCQKIRVTQGKGLMPDGTSRFTCKGKTILHYMGTSTFSEYTVVADISVAKIDPLAPLDKVCLLGCGISTGYGAAVNTAKLEPGSVCAVFGLGGVGLAVIMGCKVAGASRIIGVDINKDKFARAKEFGATECINPQDFSKPIQEVLIEMTDGGVDYSFECIGNVKVMRAALEACHKGWGVSVVVGVAASGEEIATRPFQLVTGRTWKGTAFGGWKSVESVPKLVSEYMSKKIKVDEFVTHNLSFDEINKAFELMHSGKSIRTVVKI 种属同源性预测 |
| 宿主/亚型 | Mouse / IgG1 |
| 抗体类别 | Monoclonal |
| 产品类型 | Antibody |
| 全称 | alcohol dehydrogenase 5 (class III), chi polypeptide |
| 别名 | ADH5, 5E6E2, ADH 3, ADH 5, ADH3 |
| 计算分子量 | 374 aa, 40 kDa |
| 观测分子量 | 40 kDa |
| GenBank蛋白编号 | BC014665 |
| 基因名称 | ADH5 |
| Gene ID (NCBI) | 128 |
| RRID | AB_2881587 |
| 偶联类型 | Unconjugated |
| 形式 | Liquid |
| 纯化方式 | Protein G purification |
| UNIPROT ID | P11766 |
| 储存缓冲液 | PBS with 0.02% sodium azide and 50% glycerol, pH 7.3. |
| 储存条件 | Store at -20°C. Stable for one year after shipment. Aliquoting is unnecessary for -20oC storage. |
背景介绍
ADH5, also named as ADHX, FDH FALDH GSH-FDH ADH3 and GSNOR, belongs to the zinc-containing alcohol dehydrogenase family and Class-III subfamily. It is remarkably ineffective in oxidizing ethanol, but it readily catalyzes the oxidation of long-chain primary alcohols and the oxidation of S-(hydroxymethyl) glutathione. ADH5 mediates multiple cardiovascular functions. It plays in regulating heterocellular communication in the artery wall. (PMID:21071693). ADH5 immunostaining is distributed in both the nucleus and cytoplasm of the retinal ganglion cells(PMID:22117533).
实验方案
| Product Specific Protocols | |
|---|---|
| IF protocol for GSNOR,ADH5 antibody 66193-1-Ig | Download protocol |
| IHC protocol for GSNOR,ADH5 antibody 66193-1-Ig | Download protocol |
| WB protocol for GSNOR,ADH5 antibody 66193-1-Ig | Download protocol |
| Standard Protocols | |
|---|---|
| Click here to view our Standard Protocols |
发表文章
| Species | Application | Title |
|---|---|---|
Mol Psychiatry Degradation of FA reduces Aβ neurotoxicity and Alzheimer-related phenotypes. | ||
Arterioscler Thromb Vasc Biol Arginase-1 Deletion in Erythrocytes Promotes Vascular Calcification via Enhanced GSNOR (S-Nitrosoglutathione Reductase) Expression and NO Signaling in Smooth Muscle Cells | ||
Front Physiol Maintenance of Intestinal Homeostasis in Diarrhea-Predominant Irritable Bowel Syndrome by Electroacupuncture Through Submucosal Enteric Glial Cell-Derived S-Nitrosoglutathione | ||
Alzheimers Dement (N Y) New insight into Alzheimer's disease: Light reverses Aβ-obstructed interstitial fluid flow and ameliorates memory decline in APP/PS1 mice. | ||
Eur J Pharmacol N6022 attenuates cerebral ischemia/reperfusion injury-induced microglia ferroptosis by promoting Nrf2 nuclear translocation and inhibiting the GSNOR/GSTP1 axis | ||
FASEB J Dysregulation of hepatic one-carbon metabolism in classical homocystinuria: Implications of redox-sensitive DHFR repression and tetrahydrofolate depletion for pathogenesis and treatment |